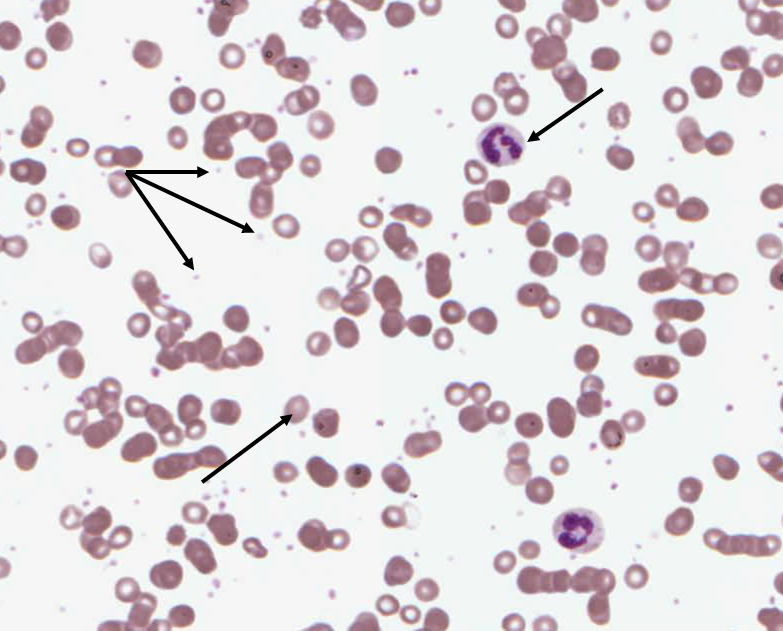

Which of the following are components of the acute inflammatory response? (there may be more than one correct response) Macrophage Infiltration Hypertrophy Lymphocyte Activation Vascular Dilatation with Hyperaemia Neutrophil Activation Hydropic Change Endothelial Activation
Macrophage Infiltration Vascular Dilatation with Hyperaemia Neutrophil Activation Endothelial Activation
Which of the following are components of the acute inflammatory exudate? (there may be more than one correct response) Collagen Plasma Cells Neutrophils Fibroblasts Fibrin Fluid
Neutrophils Fibrin Fluid
An inflammatory exudate characterised by large numbers of Neutrophils is known as?
Suppurative or Purulent.
An inflammatory exudate in which fibrin predominates is known as?
Fibrinous
An inflammatory exudate in which fluid predominates is known as?
Serous
Which of the following abnormal laboratory findings would you most expect in a patient with a florid acute inflammatory disease process? (there may be more than one correct response) Raised Sodium Decreased Haemoglobin in FBE Raised Albumin Raised ESR and CRP Raised neutrophil count in FBE
Raised ESR and CRP Raised neutrophil count in FBE
Which of the following factors are required for tissue to return to its normal structure after inflammation? (there may be more than one correct response) Removal of Injurious agent Adaptive immunity to the causative organism Adjacent connective tissue from which fibroblasts can be mobilised for scar formation Absence of trauma while healing A diet high in Iron The ability of damaged cells to regenerate An intact connective tissue network
Removal of Injurious agent Absence of trauma while healing The ability of damaged cells to regenerate An intact connective tissue network
If the injury, infection or acute inflammatory response results in destruction of connective tissue and/or the tissue type is unable to regenerate, then the only way to heal is by repair , resulting in a fibrous scar. This requires granulation tissue to form. Select which of the following options are typical components of granulation tissue. Neutrophils Granulomas ECM Lymphocytes Necrotic Debris Oedema Capillaries Myofibroblasts Multinucleate giant cells Macrophages Fibroblasts
ECM Lymphocytes Oedema Capillaries Myofibroblasts Macrophages Fibroblasts
Which cells (name 2) are characteristic of granulomatous inflammation?
Epitheloid macrophages and Multinucleate giant cells.
Pick from the list the characteristic histologic features of plasma cells. ‘Clockface’ nuclear chromatin Amphophillic cytoplasm Very small rim of cytoplasm Granular cytoplasm Bean shaped nucleus Eccentric nucleus Perinuclear Hof
‘Clockface’ nuclear chromatin Amphophillic cytoplasm Very small rim of cytoplasm Granular cytoplasm Eccentric nucleus Perinuclear Hof
What does the term ‘left shift” or “shift to the left” mean in relation to the appearance of a blood film and why does it occur?
Immature neutrophils including metamyelocytes are released from the bone marrow in response to severe inflammation. This can also occur due to severe infection.
Which of the following (more than one may be correct) are features of a myeloblast (earliest recognisable stage in granulopoiesis)? Large non-segmented nucleus Presence of nucleoli Presence of numerous cytoplasmic granules Multilobate nucleus Few cytoplasmic granules
Large non-segmented nucleus Presence of nucleoli Few cytoplasmic granules
What do fibroblasts make? (more than one answer may be correct). Fibrin Fibrinogen Collagen Elastin Glycosaminoglycans
Collagen Elastin Glycosaminoglycans
From what protein is fibrin derived and where is this protein made?
Fibrinogen, converted in the liver
In what 2 main processes is fibrin involved?
Acute inflammation and coagulation of blood